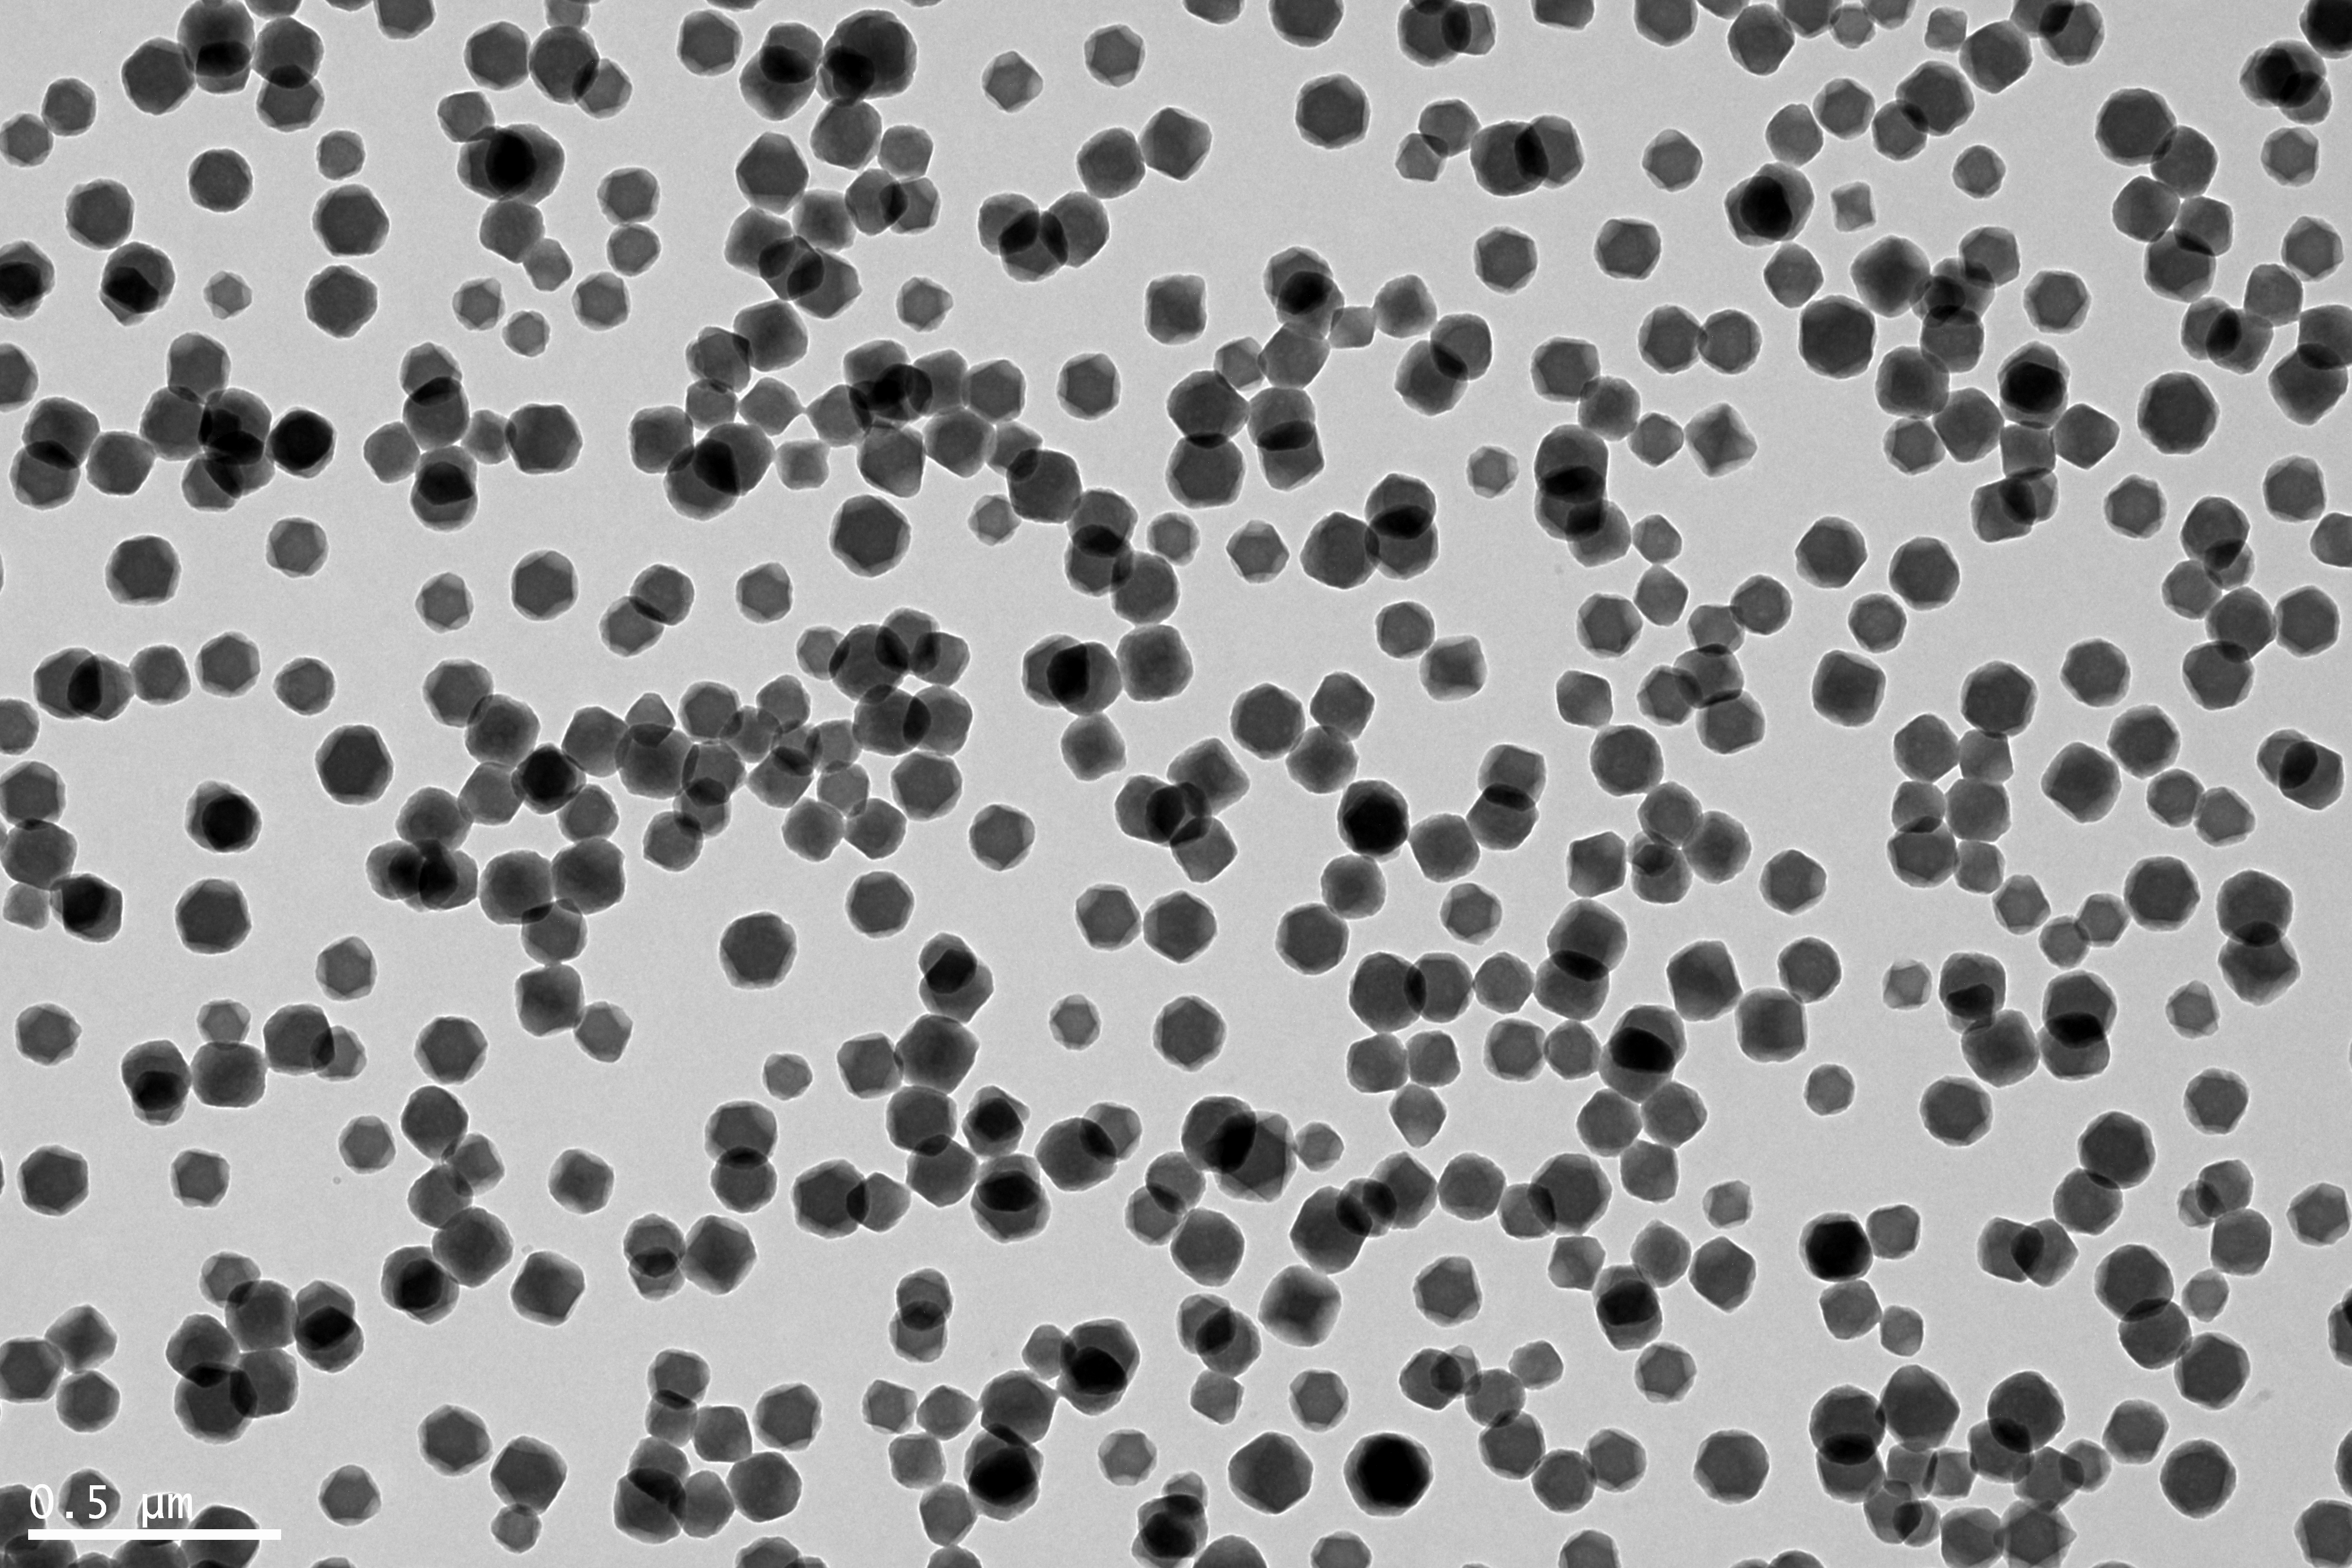

具有分级孔的金属有机骨架纳米载体药物共负载性能研究毕业论文
2020-04-06 13:09:16
摘 要
癌症,即恶性肿瘤,是当今全球药学领域前沿研究的热点。它发病原因不明,前期诊疗困难,后期难以根治,一种能够对癌症进行诊疗的方式亟待被发现。现在纳米技术迅猛发展,也带给生物医学领域一些新的方法,使用纳米粒子载体作为诊疗剂在医药学中变得越来越普遍。纳米金属骨架材料,由金属离子与配体组成,其结构容易调整、可以形成规整结晶、而且还具有极高的比表面积。在本课题的研究中,我们构建了一种可同时搭载两种药物的nMOFs(纳米金属有机骨架材料),主要研究内容和结论如下所示:
(1)研究内容:首先用苯甲酸、八水合氧氯化锆、联苯二甲酸,合成一种MOF材料UiO-67,并用透射电镜、激光粒度仪、紫外可见分光光度计等仪器对其进行一系列表征;然后用浸泡法使其负载抗癌药盐酸阿霉素(DOX),制得纳米载药粒子UiO-67@DOX,随后对其进行后续的表征。然后,通过改进合成方法来改善UiO-67粒子的比表面积与孔径,使其性能提升,进行表征后并用其进行两种药物的搭载。
(2)研究结论:紫外光谱显示改进后的纳米载药粒子HP-UiO-67能够搭载两种不同的药物,DOX与cypate,可以进行化学治疗与光治疗,透射电镜表明其具有比原来粒子包括更大的比表面积和表面孔径,在原本的粒子基础上有所改进。
关键词:纳米金属骨架;药物输送;联合治疗;癌症
Abstract
Cancer, or malignant tumor, is a research hot spot in the globe pharmaceutical field. The cause of the disease is unknown. It is difficult to diagnose and treat in the early stage and cure in the later period. One way to diagnose and treat cancer needs to be discovered. Nowadays,more and more rapid development of nanotechnology has brought new methods to the biomedical field. The use of nanoparticle carriers as therapeutic agents is becoming more and more common in medicine. Nanoscale metal-organic frameworks consists of metal ions and organic ligands, which is a new metal in the nanotechnology. Its advantage lies in: 1.Its structure is easy to adjust. 2.It can form a large crystal.3. It has a very high specific surface area. In the study of this topic, we have constructed an nMOFs (nanoscale metal-organic frameworks) ,which can carry both two different drugs at the same time.
(1)Research content: Firstly, a kind of MOF material UiO-67 was synthesized by using benzoic acid, zirconium oxychloride octahydrate and biphenyldicarboxylic acid. Then, it will be characterized by transmission electron microscope, Zetasizer Nano ZSP,UV-visible spectrophotometer and other instruments.After that, the doxorubicin hydrochloride (DOX) was loaded with anti-cancer drug by soaking method to obtain drug-loaded nanoparticle UiO-67@DOX, which was subsequently characterized. Finally, the specific surface area and pore size of UiO-67 particles were improved by improving the synthesis method, and the performance was improved. After the characterization, the two drugs were loaded.
(2)Research conclusion:UV spectroscopy shows that the improved nano drug-loaded particles HP-UiO-67 can carry two different drugs, DOX and cypate, which can be used for chemotherapy and light therapy. Transmission electron microscopy showed that it had a larger specific surface area and surface pore size than the original particles, which was improved on the basis of the original particles.
Key words:nanoscale metal-organic frameworks ,drug delivery, cancer,combination therapy
目录
第1章 绪论 1
1.1 癌症的治疗现状 1
1.2 纳米材料在药学之中的应用 2
1.3 纳米金属有机骨架材料在药学中的应用 2
1.3光疗方法在现代医学中的应用 4
1.4金属有机框架材料在光疗法中的优势 5
2 研究内容 6
第2章 实验部分 7
2.1 实验试剂与实验仪器 7
1.1.2 实验仪器 7
2.2 实验方法 8
2.2.1 UiO-67的制备 8
2.2.2 UiO-67的改进 9
2.2.2 纳米粒子粒径与形态的表征 10
2.2.3 用纳米粒子负载药物与表征 11
第3章 结果与讨论 13
3.1 UiO-67纳米粒子的制备 13
3.2 UiO-67@DOX纳米粒载药量和包封率的计算 19
3.2.1 UiO-67@DOX载药粒子的紫外可见吸收光谱: 19
3.2.2 DOX标准曲线 20
3.2.3UiO-67@DOX纳米粒载药量和包封率的测定 21
3.2.4UiO-67@cypate(近红外多次甲基菁染料)纳米粒载药量和包封率的测定 21
3.3对UiO-67纳米粒子进行改进的探究 22
3.3.1HP-UiO-67的试制条件探究: 22
3.3.2 HP-UiO-67的透射电镜图 24
3.3.3对HP-UiO-67进行搭载DOX与cypate的测试 27
第4章 结论 28
参考文献 29
绪论
1.1 癌症的治疗现状
癌症,又称恶性肿瘤,是二十一世纪人类健康所面临的最大挑战之一,是由于体内正常细胞增值、分化异常而产生的团聚体。这种细胞的生长分裂已经脱离了体内正常的调控,会迅速的生长,榨取体内大量营养物质并刺激血管向肿瘤内生长,会引起全身的营养消耗,让患者的体力、免疫力不断下降。而且随着肿瘤的发展,还会产生各种副作用,如压迫周围正常器官,堵塞体内管腔,使器官结构破坏丧失正常机能,使周围血管因缺乏供给而破裂出血,引起体内其他病菌感染等严重威胁人体正常生理状态的病人类健康收到了癌症的严重危害,在我国,根据《中国肿瘤登记年报》2017年版记载:与2012年相比,癌症新发人数继续上升,从358万增加到368万,增幅3%;同年,世界新发病例约1409万。中国新发癌症病例占世界的1/4。许多正值壮年的人因为患上恶性肿瘤而只能抱憾离世;在农村,许多户家庭因为患上恶性肿瘤,承担不起医药费而变得贫困,这对个人、家庭,甚至社会来说,都是非常严重的损失。所以如何对癌症进行更加有效率的诊断与治疗就是当前尖端领域医药研究的首要任务。当今医学治疗癌症的三种主要手段分别为手术切除、化疗、放疗[1]。在长时间的临床观察中,医学工作者发现这几种方法对于治疗癌症而言,各有不同的缺点:直接用手术切除肿瘤风险较高,不仅会带来手术创伤及术后并发症,而且对于晚期恶性肿瘤来说,四处扩散的癌细胞并不只集中在某个肿瘤内,还会扩散到身体其他各个地方,仅切除一个肿瘤并不能解决患者的病症。用化学药物治疗癌细胞,虽然能对全身的癌细胞进行抑制与杀伤,但是药物只能针对分裂分化速度快的细胞进行抑制,对于体内细胞周期短的细胞比如肠道细胞,骨髓细胞也有一定的杀伤,副作用非常明显。而且,长时间使用化学药物进行治疗会降低患者的耐受性,使患者的生理与心理都难以接受化学治疗[2]。
放射治疗是通过α、β、γ射线和各类x射线等直接照射肿瘤,使肿瘤细胞的遗传物质收到损害,抑制其分裂,或者产生电离氧杀灭癌细胞,这种治疗方法虽然比化疗更具有针对性,但是其对正常细胞的杀伤仍然存在,而且患者的顺应性依然比较差。
现代药学为了攻克癌症治疗这一难关,提出了几个新的概念,首先是对于早期癌症的诊断,越早检测,越早治疗,癌症对于人体的影响就越小。其次,是要对进行化疗的药物进行处理,降低其对正常细胞的影响,提升对肿瘤细胞的杀伤,而且是能准确的进入肿瘤中,而不是在全身不断循环,提升药物的利用率,最后还要能随时监测肿瘤细胞的治疗效果,以便不断地为患者调整其治疗方案。为了能实现这种新的概念,最好寻找一种新的材料,使其能起到这种作用[3]。
1.2 纳米材料在药学之中的应用
20世纪八十年代以来,自从证明可将物质在纳米级层面加工以来,纳米技术如同井喷一般的蓬勃发展。纳米层面在物理尺度的定义为1-100nm,当材料被加工到这个层面的时候,他的电磁性能与比表面积会大大增加,而且在这个尺度,一些量子力学的性质也开始表现。但是在药学的领域,纳米材料的尺度被定义到1-200nm或者1-1000nm,其原因是由于体内最小毛细血管的内径不会小于5μm,所以直径为1000nm的粒子就能自由的通过,而在经过肾时,肾小球只能滤过5nm以下的粒子,所以大于10nm的粒子就能避免被肾脏滤过。而且,大多数供给肿瘤细胞的血管直径在380-780nm,故在癌症治疗中我们的纳米粒子直径一般设计为100-200nm[4]。
药学在纳米技术在诞生之时就向他伸出了橄榄枝,希望能用这种新材料实现药物的递送,诊断与治疗[5]。特别是作为药物的载体,纳米材料体现出了极大的优越性,其明显优点就有以下几点:1、将药物实现靶向运输,指定运送给某些组织或细胞。2、将难以吸收的大分子药物递送进细胞膜中。3、将非极性的难溶药物进行修饰,使其能进去血液循环。4、使得药物能跨过体内的各种内部屏障,到达一般药物难以到达的地方。5、同时递送两种或更多的药物,达到联合治疗的目的。6、本身作为载体的同时成为诊断剂,或者搭载诊断剂进行实时诊疗[6]。这些优良的特性使得纳米药物载体成为了新时代药学的钻研主题之一。因此,在过去的几十年中,许多不同类型的纳米载体为此已经被开发出来了,例如无机介孔二氧化硅,金属纳米粒子(NPs)和有机胶束,脂质体和树枝状大分子[7]。但是,所有纳米载体在生物应用上都有其自身的局限性;比如脂质体,胶束和树枝状聚合物通常负载能力比较低 ,并且无机多孔材料对细胞具有毒性而且难以在体内降解。一种理想的载药系统应具备以下基本要求:载体应具有较大的载药能力;载体应该是纳米级(100-200nm)的,以便于通过静脉内给药释放药物; 载体必须具有生物相容性,它们应该是无毒的并且应该是低毒的而且容易被身体的新陈代谢消解[8]。此外,载体释放药物的速率最好能得到有效控制,达到缓释或者控释的特性。更重要的是,这种载体最好能符合目前多模式治疗系统的开发,以满足日益增长的有效治疗策略的需求。
1.3 纳米金属有机骨架材料在药学中的应用
在2015年,一种材料突然被应用于生物医学方面,就是金属-有机框架材料(metal-organic framework),这种材料由金属离子与无机非金属的配体通过配位键形成[9]。
这种材料相比与其他纳米材料,具有许多优势:1、它的组成材料有非金属与金属两种,既能具有金属离子的磁性等特征,也可以具有非金属配体的化学性质,光化学性质等特性。2、因为配合的方式多种多样,所以材料本身也具有很大的可调控性,可以适应不同的环境与要求的条件。3、通过改变桥连的配体,可以使材料具有超高的比表面积,甚至能达到94%的孔隙率,比表面积能达到7140m2/g,十分接近于理论最高值。4、对于配体可以进行不同程度的修饰,使得材料的功能性进一步的增大。5、最终形成的材料具有高度的结晶态,可以用单晶或者多晶衍射来确定其结构[10]。 现在合成金属有机框架材料的方法多种多样,这是由于材料的高度可塑性决定的,合成的方法往往直接决定了材料进行配位的方式,比如Zn2 离子,因为进入配体的多少与反应方式的不同,可以采用四配位,五配位,六配位等三种方法,而且与溶剂中的水,碱反应还可以生成Zn4O簇。换言之,设计好一种框架结构,就要同时设计出一种方法来达成这个结构。而且,因为反应中的各种因素变化,合成时很难总结出一定的基本规律,就算是能设计出一种理想的材料,在制造层面也难以实现,必须尝试各种方法条件。根据热力学的理论规律,我们可以总结出,增加反应时间与温度,有利于产生热力学产物,相反,低温与短时间有利于得到动力学的产物。而且为了能够进行进一步的分析,或者进行放大生产,合成粒子的条件最好能得出纯粹的晶体,反应的原子利用率与产率都要高。
在实验室中,制备金属有机骨架材料的的方法有:1、普通溶剂法:让金属离子与配体在常、温常压的环境下自然结合。2、溶剂热法:将金属离子与配体在高温高压下结合,促进其生长[11]。3、扩散法:将金属离子与配体分别溶解在不同的相中,通过自由扩散或者加压扩散进行反应。4、固相反应,直接在高温高压下使得金属离子与配体反应,不添加溶剂。这四种方法各有千秋,但是从经济与效率的角度考虑,实验室小规模合成材料一般采用溶剂热法进行条件的摸索与小规模制样。
在各种形成纳米金属骨架结构的金属离子中,来自过度金属族,原子序数40的锆Zr引起了越来越多的关注。在一般的条件下,Zr离子的化合价能呈现为 2、 3和 4,这种多价态的性质使得它拥有各种不同的配位方式,而且,在处于高价态的时候,金属离子会具有更小的离子半径与更高的电荷,在形成材料的时候,其热稳定性就更强,结构不会轻易破坏。锆本身在工业上未见有中毒的报道,而且若形成了稳定的材料,其生物相容性也十分的良好。据毒性评估实验表明UiO-66(Zr) [12] ,UiO-67(Zr)等基本没有生物毒性,毒性明显低于ZIF-7,ZIF-8等锌基nMOFs,因此锆基nMOFs非常适合作为药物载体,在药物递送方面具有巨大的潜力。
Lin课题组[13]使用UiO(Zr)联合递送顺铂和siRNA,并达到了极佳的顺铂化疗疗效。核磁共振(NMR)表明,顺铂前体药物通过非共价相互作用吸附在UiO的孔隙中,siRNA则通过骨架中的磷酸残基与UiO纳米粒表面上的Zr空位点进行配位结合到UiO的表面,UiO中顺铂前药的负载量为12.3wt%,siRNA的负载效率为81.6%。siRNA的包衣减弱了蛋白质的对UiO的吸附,稳定了UiO,而UiO则保护了siRNA免受核酸酶降解,促进siRNA的细胞摄取,加速siRNA从内体中逃逸出来,从而使对顺铂具有耐药性的卵巢癌细胞中的多药耐药基因沉默,在siRNA的协助下,顺铂取得了极佳的化疗效果,表明了nMOFs是一个能同时负载多种治疗药物的良好载药平台,能有效治疗多药耐药性肿瘤。Morris等人[14]制备了叠氮官能团化的UiO-66-N3 [Zr6O4(OH)4(2-N3-1,4-BDC)6]n,并通过点击反应将二苯基环辛炔(DBCO)官能团化的DNA共价连接到UiO-66-N3上得到了第一个nMOFs-核酸偶联物。流式细胞仪和共聚焦显微镜显示用UiO-66-N3-DNA纳米颗粒处理的细胞的胞内荧光水平高于用游离DNA处理的细胞,表明UiO-66-N3-DNA纳米载体的应用增加了DNA的递送量,电感耦合等离子体质谱(ICP-MS)显示UiO-66-N3-DNA纳米粒比UiO-66-N3纳米粒的细胞摄取效率更高,而且毒性实验表明UiO-66-N3-DNA纳米粒对HeLa人宫颈癌细胞没有显著的细胞毒性。以上均表明锆基nMOFs是一个良好载药平台,具有巨大的开发应用前景。(行间距不对)
1.3光疗方法在现代医学中的应用
光照疗法是一种古老的医学治疗方法,最早可追溯于在太阳光下曝晒以治疗皮肤病或者寄生虫。今天,在现代医学中光照疗法被系统的应用于治疗各种疾病,如特异性皮炎,牛皮癣,白癜风,寻常痤疮,和癌症等。但是,由于普通可见光的组织渗透性差,纯光疗只能用于浅表治疗。为了提升光照治疗的效率,许多种方法被开发出来,比如激光发生器以固定波长来提升单位辐射的能量,紫外照射提升光子的杀伤性,红外以及远红外照射能提升光的穿透性。
而且为了增强光疗的效果,一些光敏剂(PS)也被应用于体内来增强光照治疗的效果,所以又产生了:光动力疗法(PDT)和光热疗法(PTT)[15]。这两种方法是使用特定波长的光来激活光敏剂,以改善PDT和PTT的治疗效果。PDT治疗依赖于三种内在无毒成分:光敏剂,光和组织内的游离氧。通过适当波长的光照射,光敏剂被促进为激发态,其与附近的游离氧反应以产生活性氧(ROS),特别是单线态氧(1O2)。这种单线态氧能有效的杀伤肿瘤细胞,破坏其膜结构,通过局部化给予光敏剂,再光照肿瘤区域,PDT可以选择性地杀死肿瘤细胞,同时保留周围的正常组织。因此,PDT已被用于治疗许多不同种类的癌症,包括食道癌,非小细胞肺癌和头颈部癌。卟啉及其衍生物是PDT最常用的光敏剂。在PTT中,光敏剂通过光子激发到激发态,然后释放振动能量作为热量将局部温度升高到40°C以上以杀死靶细胞[16]。也是一种局部治疗,能够选择性损伤正常组织中的肿瘤,而且因为PTT治疗不依赖于局部组织的氧气含量,所以它可以用于治疗通常对PDT治疗无反应的缺氧癌症[17]。
为了进一步提高光照治疗的功效,已开发出许多功能强大的光敏剂,为了更有效的进行治疗,还需要将PS选择性递送至肿瘤部位,尽管这些新开发的光敏剂具有优异的ROS生成光化学性质,但这些PS在全身给药后肿瘤累积并不理想,并且由于它们的疏水性而倾向于在溶液中聚集,限制了光学治疗在临床中的功效。因此,需要持续将PS有效递送至肿瘤以改善PDT的治疗效果[18]。
1.4金属有机框架材料在光疗法中的优势
为了提高光疗的效果,用于搭载光敏剂的传递系统至关重要,在纳米技术崛起后,纳米粒子就被研究用来作为载体作用于目标肿瘤细胞。 目前为止,传统的纳米粒子递送系统对光敏剂在PDT中的成效较小,这是由于该类系统很难同时做到:1、优化光敏剂活性氧类的量子产率(通过减少光敏剂分子的聚集)2、选择性传递到肿瘤组织细胞内以杀死癌细胞。 临床光动力治疗的光敏剂一般采用的是卟啉及其衍生物。受此启发,美国芝加哥大学Lin课题组以具有光敏活性的卟啉配体为基元成功设计和构筑了纳米级卟啉MOFs,体外细胞和小鼠活体内研究表明:这一新型的具有光敏剂高载量的纳米MOF平台是高度有效的纳米粒子光敏剂体系,对于多种耐药性的脑和颈部肿瘤的具有很好的治疗效果[19]。该工作是自文献报道以来第一例基于纳米级MOFs材料的光动力治疗试剂。之后,Lin课题组以该纳米卟啉MOFs为结构模板,进一步构建了具有相同类似结构的基于二氢卟吩(chlorin)的纳米MOFs体系、极大提高了光敏剂的光物理性质与单线态氧的量子产率,从而显著提高了抗癌效率[20]。以上开拓性的研究表明,通过合理的设计和构筑,纳米MOFs平台可以整合传统的分子光敏剂体系,成为高效的光敏剂传输系统以提高光动力治疗的效果。
2 研究内容
通过以上介绍,金属有机骨架材料(MOFs)由于具有极大的比表面积和孔隙率、可调的孔径和形状、可控的化学结构和组成、良好的生物可降解性等优良特性,而且在于光动力治疗的方面有特异性的作用,在未来很有希望能成为一个强劲的诊疗一体化纳米平台,若能对其进行合理设计和构筑将能更大的发挥其在诊疗一体化中的应用潜力,显著改善肿瘤的治疗效果。现在我们拟研制一种具有分级孔的纳米级金属有机框架,将它作为药物载体,使其能同时负载两种抗癌药物,并在体内具有被动靶向的作用。我们的研究目标是:使研制出的纳米级金属有机框架同时具有两种不同孔径大小的微孔、不同大小的微孔能负载两种不同的药物。
以上是毕业论文大纲或资料介绍,该课题完整毕业论文、开题报告、任务书、程序设计、图纸设计等资料请添加微信获取,微信号:bysjorg。
相关图片展示: